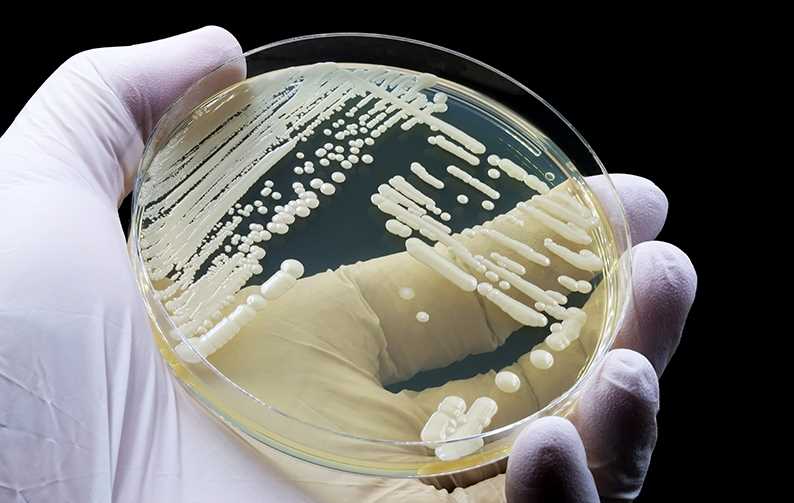
Candida Auris na placa de petri

A Candida auris é uma espécie de fungo que tem causado preocupação na área da saúde devido à sua resistência a antifúngicos comumente utilizados no tratamento de infecções por Candida spp. Além disso, sua identificação laboratorial pode ser desafiadora, o que pode levar a uma gestão inadequada de surtos nos hospitais. A divisão de Saneantes da ALS faz análises para o registro de produtos desinfetantes que auxiliam nas medidas de prevenção e controle para impedir a disseminação dessa infecção.
EPIDEMIOLOGIA DA CANDIDA AURIS
A Candida auris pode afetar pacientes de todas as faixas etárias, desde bebês até idosos internados em UTIs. Alguns fatores de risco que estão associados a infecções por Candida spp., incluem o diabetes, uso prolongado de antimicrobianos, cirurgia recente e presença de cateter venoso central. É importante ressaltar que muitos pacientes já estão em tratamento antifúngico quando a C. auris é isolada.
O tempo médio de internação à infecção por C. auris é de 17 dias, e a taxa de mortalidade varia de 60% a 100%, dependendo do contexto clínico. Na Venezuela, por exemplo, a taxa de mortalidade em bebês da UTI neonatal é de 100%.
CARACTERÍSTICAS DA CANDIDA AURIS
A Candida auris possui algumas características distintas em comparação com a Candida albicans, outra espécie comumente associada a infecções fúngicas. Enquanto a C. albicans não persiste no ambiente e é facilmente identificada, a C. auris pode persistir em superfícies e é mais difícil de ser identificada com métodos laboratoriais padrão.
A C. auris também pode colonizar diferentes regiões do corpo, como pele, boca, trato digestivo e região inguinal, e causar infecções como monilíase oral, infecção do trato urinário, infecção de corrente sanguínea e candidíase vaginal. A resistência aos antifúngicos também é mais frequente na C. auris, e a transmissão pode ocorrer não apenas pelas mãos, mas também por contato direto com superfícies e equipamentos contaminados.
PREOCUPAÇÕES COM A CANDIDA AURIS
Existem algumas razões pelas quais devemos nos preocupar com a Candida auris. Primeiramente, muitas cepas desse fungo são multirresistentes, ou seja, são resistentes a vários antifúngicos comumente utilizados no tratamento de infecções fúngicas. Algumas cepas também são resistentes a todas as três classes de antifúngicos disponíveis.
Além disso, a identificação laboratorial da C. auris pode ser desafiadora, especialmente em laboratórios sem tecnologia específica. A identificação incorreta pode levar a uma gestão inadequada de surtos nos hospitais. Por fim, a C. auris tem causado surtos em ambientes de saúde, por isso é essencial identificar rapidamente a presença desse fungo em pacientes hospitalizados para que sejam tomadas precauções especiais para evitar sua disseminação.
TRANSMISSÃO DE CANDIDA AURIS NO AMBIENTE HOSPITALAR
A transmissão da Candida auris em ambiente hospitalar ocorre por meio de reservatórios, como pacientes colonizados ou infectados, e pode ocorrer tanto por contato direto com esses pacientes quanto por meio de superfícies e equipamentos contaminados. A colonização pelo fungo pode levar à infecção em pacientes suscetíveis, resultando em um quadro clínico mais grave.
Para prevenir a transmissão de C. auris, é essencial adotar medidas de controle, como adesão à higiene das mãos, uso adequado de precauções de contato, limpeza e desinfecção do ambiente de atendimento ao paciente, comunicação entre estabelecimentos de saúde e vigilância laboratorial de contatos e amostras clínicas.
IMPORTÂNCIA DO AMBIENTE NA PREVENÇÃO DE SURTOS
O ambiente hospitalar desempenha um papel importante na transmissão de C. auris. O fungo pode persistir em superfícies e equipamentos, por isso a descontaminação do ambiente é essencial para prevenir surtos. Além disso, é importante individualizar os equipamentos médicos utilizados por pacientes com C. auris e realizar a limpeza e desinfecção adequadas das superfícies.
Existem produtos registrados junto à ANVISA com atividade comprovada contra C. auris, como o hipoclorito de sódio, o peróxido de hidrogênio e o álcool isopropílico. Na escolha de um produto deve ser observada e seguida a indicação de rotulagem quanto a diluição correta e tempo de contato, além do prazo de validade.
ANÁLISES DE EFICÁCIA DE PRODUTOS DESINFETANTES
A divisão de produtos Saneantes da ALS conduz avaliação de eficácia de produtos desinfetantes hospitalares frente a Candida auris, utilizando metodologia recomendada e acreditada pelas Boas Práticas de Laboratórios.
Para obter mais informações sobre as análises de eficácia para produtos saneantes hospitalares, escreva para saneantes.br@alsglobal.com